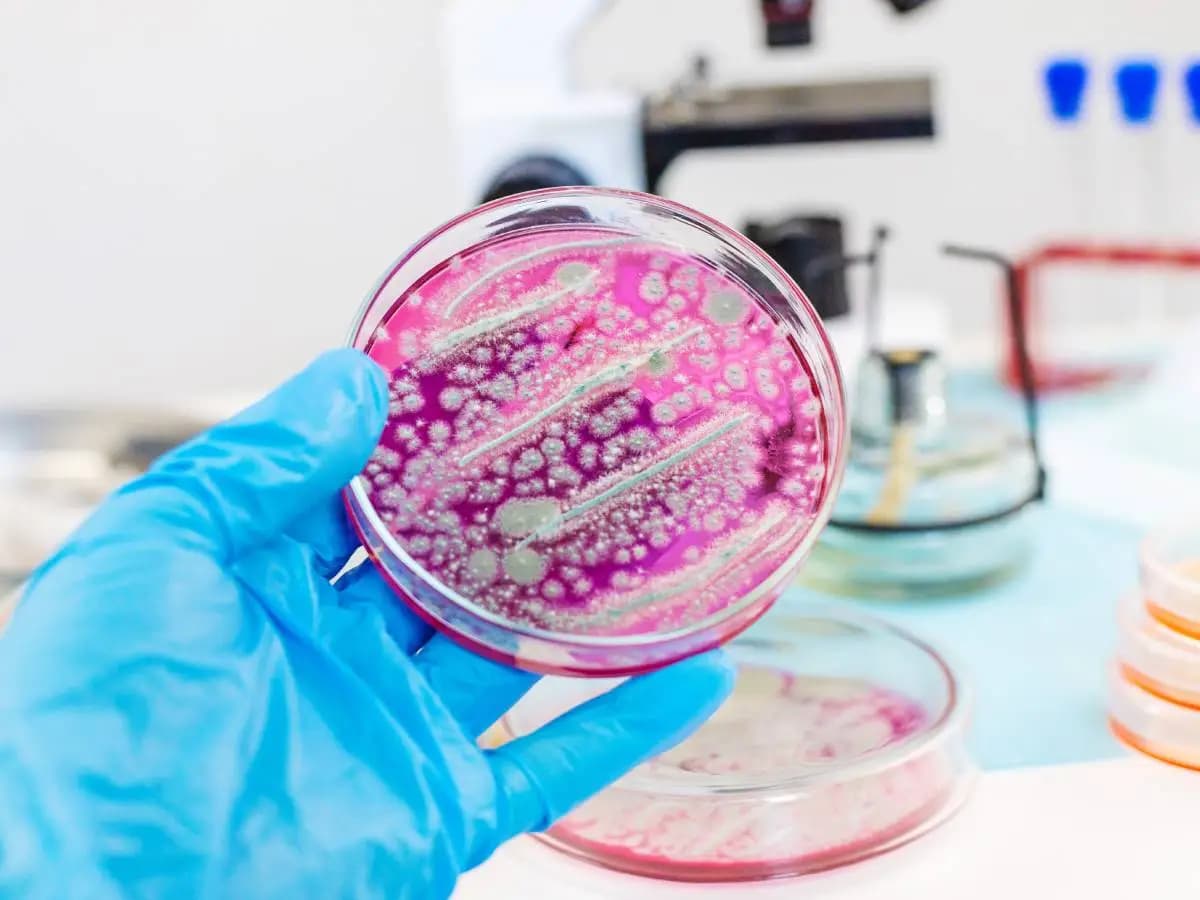
Batteri, la resistenza agli antibiotici è collegata anche ai ghiacci

Batteri, la resistenza agli antibiotici è collegata anche ai ghiacci
I batteri stanno diventando sempre più resistenti agli antibiotici quindi combatterli risulta a volta complicato. Secondo un nuovo studio pubblicato in Biocontaminant la colpa del fenomeno è da attribuire anche allo scioglimento dei ghiacci, che appaiono dei serbatoi del gene che conferisce ai microrganismi tale capacità. Non tutte le regioni sono protagoniste della dinamica nella stessa misura ma un attento monitoraggio appare imprescindibile.
I batteri resistono agli antibiotici?
Gli antibiotici sono farmaci nati per debellare i batteri ma negli ultimi anni i microrganismi stanno imparando a difendersi. Pratiche ospedaliere e mediche sorrette, allevamenti intensivi in cui l’uso di farmaci è massiccio e trattamenti non idonei delle acque di scarto rientrano tra le cause del problema ma oggi al puzzle si aggiunge un ulteriore tassello.
A creare problemi sono anche i ghiacciai. Questi fungono da serbatoi dei geni di resistenza e, con il loro scioglimento causato dalla continua corsa del cambiamento climatico, li liberano. Pur trovandosi spesso in aree isolate, i giganti bianchi alimentano poi fiumi e laghi con le proprie acque. Permettono dunque a tale tratto di circolare anche in zone ampiamente popolate.
Lo studio sui batteri resistenti agli antibiotici
A concentrarsi sul collegamento tra scioglimento dei ghiacci e batteri resistenti agli antibiotici ci ha pensato un team della Lanzhou University. I ricercatori hanno combinato una vasta gamma di paper pubblicati nel tempo sull’argomento per poi sintetizzare le conclusioni individuando dei trend. Ne è emerso che i giganti bianchi fungono da archivio per quanto riguarda i geni di resistenza agli antibiotici ARG.
In essi si combinano sia tracce genetiche antiche, sia evoluzioni connesse alle attività umane. Nell’Artico la presenza dei geni di resistenza è risultata due volte più massiccia rispetto a quella individuata in Antartide. Il gap è dovuto alla differenza di interazione tra uomo e ambiente. Anche nell'Altopiano del Tibet la situazione si è dimostrata preoccupante.
Cosa fare per i batteri resistenti agli antibiotici?
La presenza di geni di resistenza agli antibiotici individuati nei ghiaccii non compete con i dati sui batteri registrati altrove, in aree più densamente popolate. Lo studio scardina però alcune certezze. Appare evidente infatti che considerare i ghiacciai come luoghi isolati e incontaminati non è più possibile. I dati appaiono poi clinicamente rilevanti.
Nel Canada Artico sono stati isolati per esempio batteri in grado di difendersi da antibiotici oggi comunemente in uso come cefazolina e cefamandolo. Gli autori propongono ora di condurre un’analisi sistematica su tutti gli ambienti glaciali, sfruttando la metagenomica. Un lavoro simile è però possibile solo all’interno di un’azione coordinata a livello internazionale.
L’interesse per i batteri resistenti agli antibiotici è in continua crescita in modo esponenziale negli ultimi 15 anni. Ora però la priorità appare quella di inserire tutte le indagini all’interno di un sistema di monitoraggio e di allerta precoce, che permetta alle autorità sanitarie locali e internazionali di organizzarsi in maniera opportuna per evitare che le contaminazioni ambientali si trasformino in concrete emergenze di salute pubblica.
Le informazioni contenute in questo articolo sono da intendersi a puro scopo informativo e divulgativo e non devono essere intese in alcun modo come diagnosi, prognosi o terapie da sostituirsi a quelle farmacologiche eventualmente in atto. In nessun caso sostituiscono la consulenza medica specialistica. L’autore ed il sito declinano ogni responsabilità rispetto ad eventuali reazioni indesiderate.






